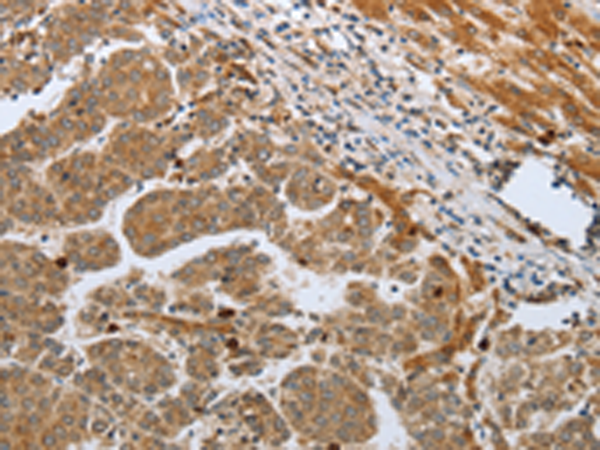
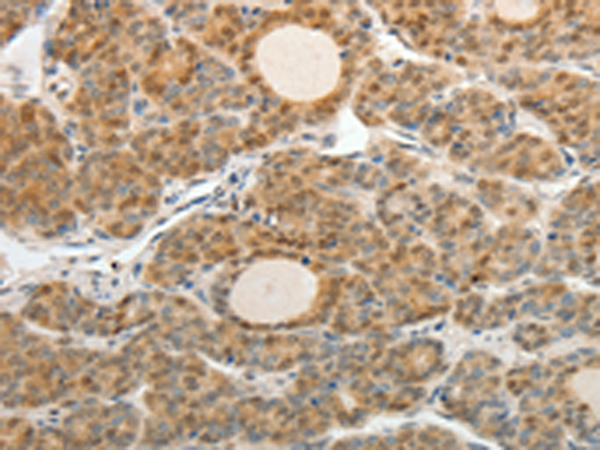

-
分类: 科研抗体货号: P10729别名: CASP-12, CASP12P1应用: WB,IHC反应种属: Human, Mouse
-
分类: 科研抗体货号: P10708别名: ASH1; HASH1; MASH1; bHLHa46应用: IHC反应种属: Human, Mouse, Rat
-
分类: 科研抗体货号: P10727别名: FAD, FACD, FAD1, GLM3, BRCC2, FANCB, FANCD, PNCA2, FANCD1, BROVCA2应用: IHC反应种属: Human
-
分类: 科研抗体货号: P10745别名: CEA cell adhesion molecule 5,CEA, CD66e应用: IHC反应种属: Human
-
分类: 科研抗体货号: P10725别名: BNP; Iso-ANP应用: IHC反应种属: Human
-
分类: 科研抗体货号: P10743别名: CDC18L; HsCDC6; MGORS5; HsCDC18应用: WB,IHC反应种属: Human
-
分类: 科研抗体货号: P10723别名: KGF; HBGF-7应用: IHC反应种属: Human, Mouse, Rat
-
分类: 科研抗体货号: P10742别名: P50CDC37应用: WB,IHC反应种属: Human, Mouse, Rat
-
分类: 科研抗体货号: P10763别名: CNCG, CNG1, RP49, CNCG1, CNG-1, RCNC1, RCNCa, RCNCalpha应用: IHC反应种属: Human
-
分类: 科研抗体货号: P10741别名: BLR2, EBI1, CD197, CDw197, CMKBR7应用: WB反应种属: Human

鄂公网安备42018502007531号
鄂公网安备42018502007531号

